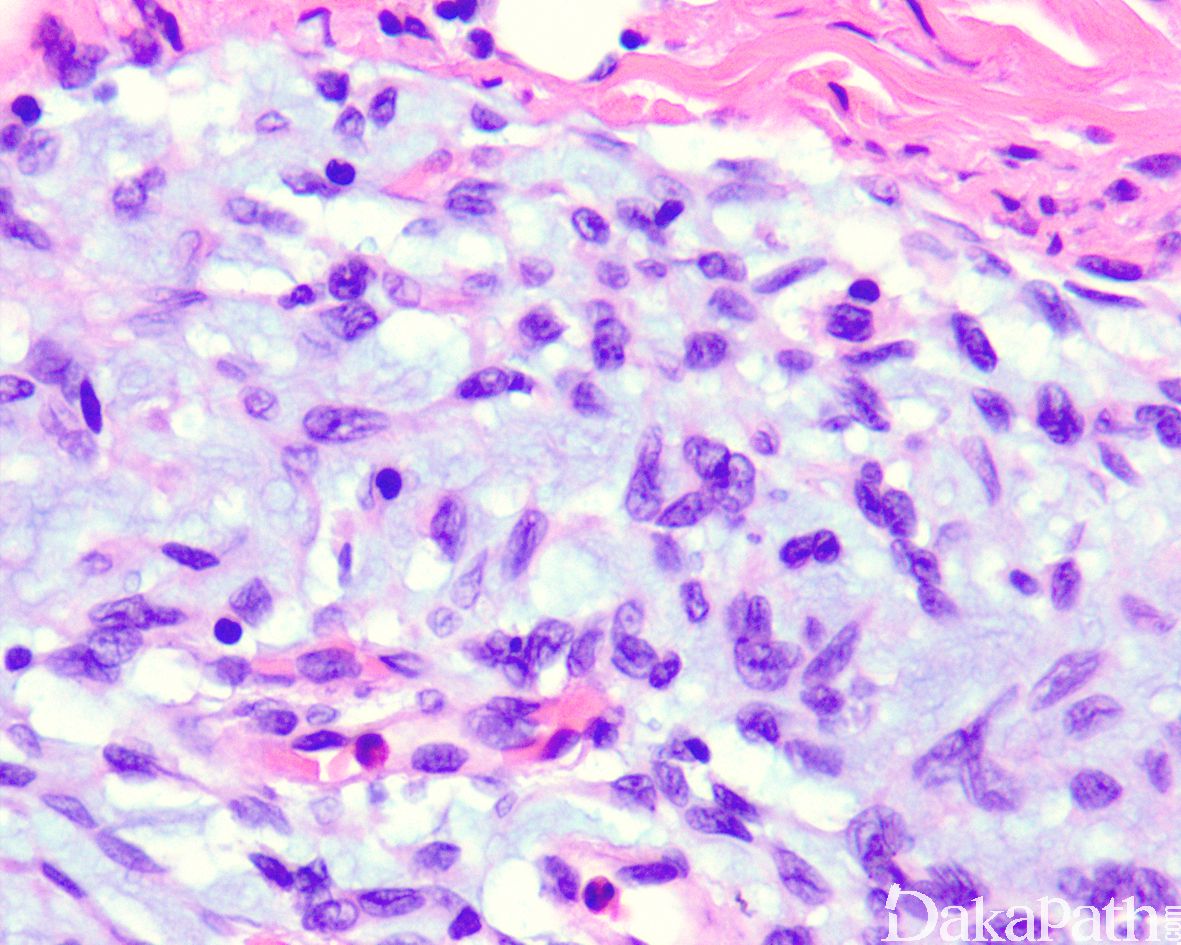

婴儿纤维性错构瘤
Fibrous Hamartoma of Infancy,FHD
同义词(或曾用名): 婴儿真皮下纤维瘤样肿瘤
概述:
一种发生于婴儿的浅表性软组织肿瘤,镜下主要由三种成分构成包括:成熟的脂肪、呈梁状生长的纤维瘤病样梭形细胞以及结节状聚集的原始间叶性细胞。
发病部位: 好发腋窝,其次为上臂、肩部、胸壁、背部和腹股沟,以及前臂、臀部和外生殖区,偶可位于手腕、手指和头皮等处。
诊断要点:
23%为先天性发病,91%在 1 岁以内发病,仅有 4%发生于 2 岁以后,男/女约 2:1,病变通常为孤立发生,瘤体直径 0.5-20cm,平均直径通常小于 5cm,切面边界不清,灰白灰黄色;
镜下位于真皮深层或皮下,边界不清;由致密梭形细胞、原始间叶细胞和成熟脂肪组织组成,不同病例三者比例不同:
致密的纤维组织由比较成熟的纤维母细胞、肌纤维母细胞和胶原纤维组成,呈纵横交错的束状排列,常呈指状伸入脂肪组织内,组织学类似于纤维瘤病;部分区域可见梭形细胞之间成片的胶原化或瘢痕化以及多核巨细胞沉积,类似于乳腺的假血管瘤样增生或巨细胞纤维母细胞瘤样改变;
原始间叶组织呈结节状分布,由幼稚的短梭形、卵圆形或星状细胞排列成呈疏松的漩涡状、巢状或宽带状包被于富于血管的黏液性基质之间;
瘤细胞形态均教温和,核异型性轻微,罕见核分裂象;
偶尔显示高级别肉瘤样转化,表现为原始小圆或短梭形瘤细胞密度增高,伴有明显的核异型性以及活跃的分裂象。

免疫组织化学染色:
纤维瘤病样的梭形细胞局灶表达 CD34 和 SMA,罕见表达 desmin,无核表达 b-catenin;脂肪组织表达 S100 蛋白,不成熟的间叶性成分表达 CD34 和 bcl2,病变细胞不表达 CK,EMA, MyoD1 等。
分子标记:
EGFR 基因 20 号外显子插入/重复突变
鉴别诊断:
1. 婴儿纤维瘤病: 多发生在肌内,界限不清,无器官样排列结构。
2. 钙化性腱膜纤维瘤: 不见于婴儿,病变多位于手掌,可见散在的软骨小岛;
- 脂肪纤维瘤病:纤维瘤病样的梭形细胞排列更致密和有序,与脂肪交界处常见假脂肪母细胞,无漩涡状生长的结节状原始间叶性成分。
预后:
多数预后较好,偶尔复发,尤其是伴有高级别肉瘤样转化者。
治疗:
局部完整切除
参考文献:
Saab S T , Mcclain C M , Coffin C M . Fibrous hamartoma of infancy: a clinicopathologic analysis of 60 cases.[J]. American Journal of Surgical Pathology, 2014, 38(3):394-401. EGFR Exon 20 Insertion/Duplication Mutations Characterize Fibrous Hamartoma of Infancy .
Park JY, Cohen C, Lopez D, Ramos E, Wagenfuehr J, Rakheja D.
Am J Surg Pathol. 2016 Dec;40(12):1713-1718. Fibrous** hamartoma of infancy : a clinicopathologic study of 145 cases, including 2 with sarcomatous features.
Al-Ibraheemi A, Martinez A, Weiss SW, Kozakewich HP, Perez-Atayde AR, Tran H, Parham DM, Sukov WR, Fritchie KJ, Folpe AL.
Mod Pathol. 2017 Apr;30(4):474-485. doi: 10.1038/modpathol.2016.215. Epub 2017 Jan 6.
← 肢端黏液炎症性纤维母细胞肉瘤 结节性筋膜炎 →
